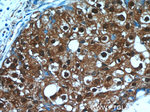
C6orf211 Antibody in Immunohistochemistry (Paraffin) (IHC (P))
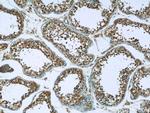
C6orf211 Antibody in Immunohistochemistry (Paraffin) (IHC (P))

Search
Proteintech
C6orf211 Polyclonal Antibody
{{$productOrderCtrl.translations['antibody.pdp.commerceCard.promotion.promotions']}}
{{$productOrderCtrl.translations['antibody.pdp.commerceCard.promotion.viewpromo']}}
{{$productOrderCtrl.translations['antibody.pdp.commerceCard.promotion.promocode']}}: {{promo.promoCode}} {{promo.promoTitle}} {{promo.promoDescription}}. {{$productOrderCtrl.translations['antibody.pdp.commerceCard.promotion.learnmore']}}
产品信息
25124-1-AP
种属反应
宿主/亚型
分类
类型
抗原
偶联物
形式
浓度
纯化类型
保存液
内含物
保存条件
运输条件
产品详细信息
Immunogen sequence: YLEYQQSLL NESDGKSRWF YSPWLLVECY IDRRIHEAII QSPPIDYFDV FKESKEQNFY GSQESIIALC THLQQLIRTI EDLYENQLKD EFFKLLQISL WGNKCDLSLS GGESSSQNTN VLNSLEDLKP FILLNDMEHL WSLLSNCKKT REKASATRVY IVLDNSGFEL VTDLILADFL LSSELATEVH FYGKTIPWFV SDTTIHDFNW LIEQVKHSNH KWMSKCGADW EEYIKMGKWV YHNHIFWTLP HEYCAMPQVA PDLYAELQKA HLILFKGDLN YRKLTGDRKW EFSVPFHQAL NGFHPAPLCT IRTLKAEIQV GLQPGQGEQL LASEPSWWTT GKYGIFQYDG (91-439 aa encoded by BC011348)
靶标信息
ARMT1 gene ontology annotations related to this gene include protein carboxyl O-methyltransferase activity.
仅用于科研。不用于诊断过程。未经明确授权不得转售。
篇参考文献 (0)
生物信息学
蛋白别名: Acidic residue methyltransferase 1; Damage-control phosphatase ARMT1; Protein-glutamate O-methyltransferase; Sugar phosphate phosphatase ARMT1; UPF0364 protein C6orf211
基因别名: ARMT1; C6orf211
UniProt ID: (Human) Q9H993
Entrez Gene ID: (Human) 79624